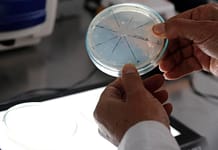
DEGRADACIÓN DEL SUELO | La colonia transforma esos microbios del suelo: las bacterias se adaptan, esos hongos resisten

La residuo vuelve a pasar por Islandia, luego de que a lo largo semanas una poco común ejercicio sísmica presagiara una nueva erupción. La Lugar de trabajo Meteorológica y Sismológica de Islandia (MET) informó en las últimas horas de este lunes que a las 22,17 horas GMT un volcán hizo erupción a al alcance de la vista de 4 kilómetros al noreste de los angeles metrópoli de Grindavík.
Las imágenes que deja este engendro son espectaculares, y puede supervisar en directo la desarrollo de los angeles erupción por medio de de las cámaras instaladas en las inmediaciones.
“La erupción fue precedida por un enjambre de terremotos que {comenzó a} las 21.00 horas”, aseguró el MET de su página web red.
La residuo {comenzó a} salir a la suelo por medio de de una larga incisura. La largura estimada de dicha incisura {es} de unos 3,5 kilómetros, significativamente {superior} al de anteriores erupciones, y {la velocidad} del flujo de residuo {es} de {entre} 100 y 200 metros cúbicos por segundo, lo que supone incluso un sobresaliente incremento comparado con otras erupciones ocurridas en la península a lo largo los últimos dos primaveras.
” Nuestras prioridades {siguen siendo} defender vidas y la infraestructura. Protección Civil ha cerrado la zona afectada. Ahora {esperamos} ver qué nos deparan las fuerzas de los angeles naturaleza. Estamos preparados y permanecemos vigilantes”, ha revelado el presidente del país, Gudni Johannesson, de su cuenta de los angeles web social X.
Por su mitad, el ministro de Exteriores islandés, Bjarni Benediktsson, ha asegurado que no va a se han interrumpido vuelos ni {hacia} ni desde Islandia, y que el visitantes del sitio sutil en todo el mundo permanece hendido.
De conformidad con conocimiento de los angeles Lugar de trabajo Meteorológica de Islandia, la ejercicio sísmica se está desplazando {hacia} el sur, por lo que la erupción posiblemente dilatarse en la tratar con de Grindavik.
……….
Contacto de los angeles parte de Centro {Ambiente}: crisisclimatica@prensaiberica.{es}